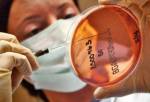

7 изключително опасни причини за новата епидемия – безсънието
09 март 2017 09:28
Краят на зимата носи със себе си не само температурни промени, но и изтощително безсъние. Като правило то е предизвикано от стреса при... » повече
0 коментара
10265 прочита
09 март 2017 09:28



Доц. Груев: “Около половината от населението в България е с наднормено тегло.“
08 март 2017 09:22
Проблемът е изключително голям в световен мащаб и за съжаление, все по-актуален и в нашата страна, защото проучванията показват, че... » повече
0 коментара
6291 прочита
08 март 2017 09:22



5 симптома, че прекалявате със солта
08 март 2017 09:09
Ако се храните с твърде много сол, това може да навреди на вашето здраве. Преди това обаче вашето тяло ви дава редица предупредителни... » повече
0 коментара
12078 прочита
08 март 2017 09:09



Какво се случва, когато откажете закуската?
07 март 2017 09:53
Може би сутрин хапвате набързо нещо сладко и кафе? Но след като се събуди, организмът има нужда да стартира процеса на работа на мозъка... » повече
0 коментара
15750 прочита
07 март 2017 09:53



Задухът докарва инфаркт
07 март 2017 09:51
Да се разпознае развиващо се сърдечно заболяване в самото начало, е трудно, защото болестите на сърдечносъдовата система имат... » повече
0 коментара
12222 прочита
07 март 2017 09:51



Във всяка градина ще ги намерим. Билки за здраве
07 март 2017 09:41
Вълшебните свойства на билките сякаш са безкрайни. В природата са скрити хиляди малки съкровища, които просто трябва да се научим да... » повече
0 коментара
7961 прочита
07 март 2017 09:41



Полезните храни, които съсипват кожата
07 март 2017 09:22
Храните се здравословно, давате луди пари за всякакви козметични продукти, но кожата ви продължава да бъде проблемна. Истината е, че... » повече
0 коментара
7794 прочита
07 март 2017 09:22



9 ползи за здравето от ябълковия оцет
06 март 2017 09:53
Какви ползи за здравето ни крие ябълковия оцет? Как да го приемаме за по-добро храносмилане, за повече енергия или при болно... » повече
0 коментара
9959 прочита
06 март 2017 09:53



Лекарският съюз: Ако българите не започнат да се интересуват за какво се харчат парите им, ще продължи отклоняването на средства
06 март 2017 09:33
Ако българските данъкоплатци не започнат да се интересуват за какво се харчат парите им, ще продължи отклоняването на средства не в... » повече
0 коментара
7511 прочита
06 март 2017 09:33



Предизвикайте себе си за 3 дни: Ще видите какво прави това чудо с фигурата и здравето ви! (рецепта)
06 март 2017 09:21
Лятото наближава и всеки иска да го посрещне в добра форма. Това природно чудо обаче, не е само за отслабване, но и предимно за здраве. То... » повече
0 коментара
16817 прочита
06 март 2017 09:21



Слагат край на ненужния престой по болниците
06 март 2017 09:12
Край на ненужния престой в болниците. В момента, за да успеят лечебните заведения да вземат парите си по клинична пътека, задържат... » повече
0 коментара
14472 прочита
06 март 2017 09:12



За кого постенето е противопоказано
05 март 2017 09:25
От четирите по-дълги поста, които спазват православните християни, Великденският е най-важният, най-дългият и най-строгият. Той... » повече
0 коментара
6890 прочита
05 март 2017 09:25